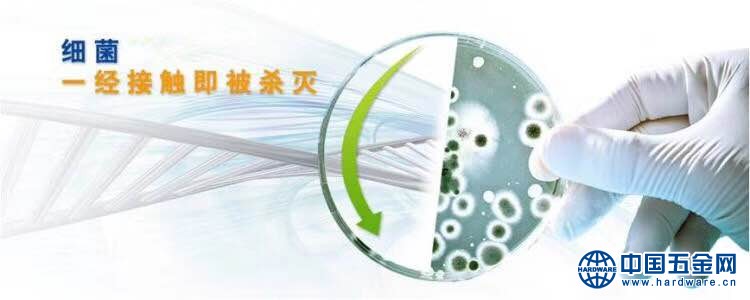

PHMG杀菌剂 PHMG-25%聚六亚甲基胍盐酸盐
产品介绍:
蓝峰PHMG-25%是环保型高分子聚合物杀菌消毒剂——聚六亚甲基胍,具有杀菌广谱;有效浓度低;作用速度快;性质稳定;易溶于水的优良性能;可在常温下使用;长期抑菌、无副作用;无腐蚀性;无色、无嗅;无毒;不燃、不爆、使用安全;价格适中;运输方便,可以说是Z佳的杀菌剂。事实上,蓝峰PHMG-25%是一种环保型多用途新型聚合物,在工业、农业、医用和日常生活中有着极其广泛的用途。
作用方式、机理:
蓝峰PHMG-25%为多胍类高分子聚合物,在水溶液中能产生电离,它的亲水基部分含有强烈的正电性,吸附通常呈负电性的各类细菌、病毒,进入细胞膜,抑制膜内脂质体合成,造成菌体凋亡,达到Z佳的杀菌效果。
化学组成:聚六亚甲基胍盐酸盐/磷酸盐
商品名:PHMG
分子结构式:
分子式: (C7H15N3)n·(HCl) x
CAS:57028-96-3
质量指标:
|
项目 |
指标 |
|
外观 |
无色至淡黄色透明液体 |
|
活性物含量 |
≥25% |
|
相对密度(25℃) |
1.01-1.05 |
|
pH值(1%水溶液) |
6.5~8.0 |
|
炽灼残渣 |
≤0.1% |
|
溶解性 |
易溶于水,溶于低级醇 |
应用:
可用于湿巾、护理洗液、洗手液、皮肤护理品等各种抗菌、消毒配方,特别适用于卫生湿巾。
可用于化妆品、护肤品、抗菌洗液、婴幼儿皮肤护理品、水产养殖,家庭专用杀菌消毒剂,皮肤、创面消毒剂,可用于妇科洗液,用于公共场所灭菌净化剂,用于纺织行业及卫生巾等制品杀菌消毒,
可用于工业水处理巾的杀菌灭藻。
配伍性:避免与皂类、阴离子表面活性剂、氧化性物质等一起使用
抗菌性能:
广谱抗菌、杀菌,能高效杀灭抑制革兰氏阴性菌、阳性菌、酵母菌和藻类。
用量及特点:
1. 一般建议添加量为0.1-1.0% ,pH值使用范围3~9。
2. 安全性出色,对眼、皮肤、粘膜无刺激,无过敏。
3. 与尼泊金酯、IPBC等配合使用,可增强其防腐效果
4. 可在室温或高温(100℃)下使用,避免与皂类、阴离子表面活性剂、氧化性物质等一起使用。
5. 对于不同的应用领域,产品的用法用量有较大差异,建议在本公司专业技术人员指导下使用。
毒性试验:
急性经口毒性试验(小鼠):LD50>5000mg/kg
急性眼刺激性试验(家兔): 无刺激性(0.25%浓度)
皮肤刺激性试验(家兔)无刺激性(0.25%浓度)
阴道粘膜刺激试验(大鼠):无刺激性(0.25%浓度)
微核试验(小鼠):无致微核作用(0.25%浓度)
在正常使用浓度下,无过敏,对皮肤及眼睛无刺激性。
包装规格: 纸箱:5.0kg×4罐/箱 25公斤/桶
贮存:在避光、阴凉、干燥处,室温密闭保存。
保质期:常温、防潮、密封、避光。保质期24个月。
产品包装、规格:25KG塑料桶


